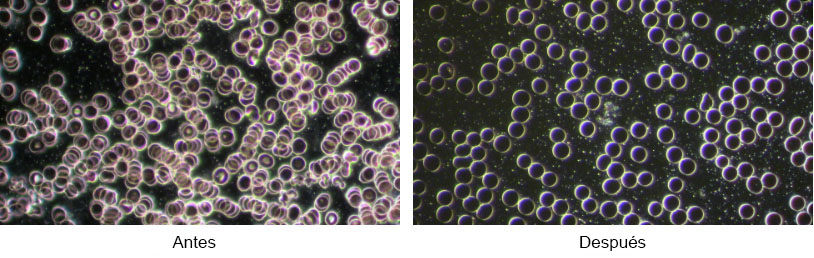

Laser frío de muñeca Spooky2
Spooky2 trae al hogar un método de láser frío conveniente y asequible utilizando tecnología láser moderna de estado sólido.
El Laser Frío Spooky2 está disponible en 2 modelos, cada uno con cables adaptadores que se conectan directamente a su generador Spooky2-XM.
Esta es nuestro Laser frío de muñeca Spooky2 con 5 láseres de 5 mW y 650 nm que proporcionan frecuencias de equilibrio de energía directamente a la sangre y al túnel carpiano.
También tenemos el Láser frío doble Spooky2 aquí.
Especificaciones del láser frío Spooky2
Voltaje máximo: 10v (-100% de compensación)
Impedancia mínima de la fuente: 50 ohmios
Frecuencia máxima: 1MHz
Potencia óptica nominal: 8 mW máximo
Rango de corriente de funcionamiento: 12 mA – 23 mA
Características ópticas:
Longitud de onda: 640 nm – 650 nm
Divergencia del haz: 8 grados
Contexto del Laser frío
El método de láser frío, o solución de láser de bajo nivel, es un equilibrador de energía que utiliza una longitud de onda de luz específica y precisa para interactuar con el tejido. Esto ayuda a acelerar el proceso de equilibrio energético natural del cuerpo. Las personas que padecen una variedad de afecciones agudas y crónicas pueden utilizar el método láser frío para ayudar a eliminar el dolor, la hinchazón, reducir los espasmos y aumentar la funcionalidad.
Los láseres fríos son láseres de baja potencia que proporcionan fotones de luz no térmicos. Estos fotones atraviesan la dermis, la epidermis y el tejido subcutáneo o tejido adiposo debajo de la piel. A menudo se utilizan durante hasta 30 minutos seguidos, aunque las duraciones más largas para equilibrar la energía no causan efectos adversos.
La energía luminosa se absorbe e interactúa con los elementos sensibles a la luz dentro de la célula. Este proceso es muy similar a la fotosíntesis en las plantas. La luz del sol es absorbida por las plantas, que luego se convierte en energía para que la planta crezca.
La energía luminosa absorbida por las células permite que cada célula se “normalice”. Este aumento del metabolismo intracelular da como resultado una reducción del dolor, la inflamación, el edema y una reducción del tiempo de equilibrio energético. Los fotones absorbidos por las células a través de un método láser estimulan las mitocondrias para acelerar la producción de ATP. Este aumento bioquímico de la energía celular se utiliza para transformar las células vivas de un estado de enfermedad a un estado estable y saludable.
El método de láser frío puede estimular la mayoría de los tipos de células, incluidos músculos, ligamentos, cartílagos, nervios y muchos más. El método de láser frío es útil para:
- Regeneración ósea
- Síndrome del túnel carpiano
- Dolor dental
- Hipersensibilidad dentinaria
- Trastornos del codo
- Fibromialgia
- Herpes labial
- Artrosis de rodilla
- Linfedema
- Disfunción musculoesquelética
- Síndrome de dolor miofascial
- Disfunciones neurológicas
- Alivio del dolor (por ejemplo, dolor lumbar/dolor de cuello agudo y crónico, dolor de ortodoncia, dolor de hombro)
- Síndrome de dolor rótula-femoral
- Solución física (incluida la rehabilitación después de la liberación del túnel carpiano)
- Estomatitis aftosa/úlceras recurrentes
- Artritis reumatoide
- Síndrome de pinzamiento del hombro
- Trastornos de la articulación temporomandibular
- Tinnitus
- Recuperación de heridas (incluidas úlceras diabéticas y recuperación gingival)
Efectividad del láser frío
Los médicos han estado utilizando un método de láser frío durante más de 40 años en pacientes que buscan métodos alternativos eficaces para aliviar el dolor. Más de 2500 estudios clínicos publicados en todo el mundo desde 1967. La mayoría de estos estudios fueron doble ciego y controlados con placebo. Demostraron claramente la eficacia del método de láser frío para aliviar el dolor.
El Grupo de Trabajo sobre el Dolor de Cuello y las Articulaciones de la Década 2000-2010 revisó la eficacia del método de láser frío para el dolor de cuello. La revisión concluyó que el método láser de bajo nivel es un valioso equilibrador de energía para muchas condiciones.
Ventajas del método de láser frío
El método de láser frío es un procedimiento no invasivo que no requiere una incisión quirúrgica.
Sin tiempo de recuperación prolongado.
No se requieren medicamentos adicionales.
No hay efectos secundarios graves cuando se usa correctamente.
Respaldado por múltiples estudios médicos.
Desventajas del método de láser frío
- Es posible que sean necesarios varios equilibrios energéticos antes de que se observe alguna mejora.
- Las lesiones antiguas pueden irritarse inicialmente durante las etapas iniciales del equilibrio energético.
- Caro.
Las ventajas de Spooky2
- Conveniente.
- Asequible.
- Calidad.
- Control de frecuencia.
Echemos un vistazo a las imágenes de antes y después de las células sanguíneas usando 45 minutos con una aplicación de láser frío para células sanguíneas.
Los láseres fríos pueden ser pulsados por frecuencias para acelerar el equilibrio energético. Los siguientes estudios demuestran la mayor eficacia utilizando frecuencias:
[J Rehabil Res Dev. 2009;46(4):543-54.]
El método láser de bajo nivel con láser infrarrojo pulsado acelera el proceso de equilibrio de energía de quemadura de tercer grado.
Resumen
Este estudio investigó la influencia de un método de láser pulsado de baja intensidad en el equilibrio energético de una quemadura de tercer grado en un modelo de rata. Se realizaron dos quemaduras de tercer grado (distal y proximal) en la piel de 74 ratas. Las ratas se dividieron en cuatro grupos. En el grupo 1, la quemadura distal recibió LLLT con el láser apagado; en los grupos 2 y 3, las quemaduras distales fueron atendidas con un láser de diodo infrarrojo pulsado a 3.000 Hz con densidades de energía de 2,3 y 11,7 J/cm2, respectivamente. En el grupo 4, las quemaduras distales fueron atendidas tópicamente con nitrofurazona al 0,2%. La quemadura proximal de todos los grupos se consideró una quemadura de control. Evaluamos la respuesta a los equilibrios energéticos tanto microbiológica como macroscópicamente. La prueba de chi-cuadrado mostró que la incidencia de Staphylococcus epidermidis, Lactobacillus y difteria disminuyó significativamente en los grupos ayudados por láser en comparación con otros grupos. La prueba t de muestra independiente mostró que la LLLT con una densidad de energía de 11,7 J/cm(2) aumentó significativamente la tasa de cierre de la herida a las 3 y 4 semanas después de la quema en comparación con sus quemaduras de control relevantes (p = 0,018 y p = 0,01, respectivamente). La LLLT pulsada con 11,7 J/cm(2)/890 nm de una quemadura de tercer grado en un modelo de rata aumentó significativamente la tasa de cierre de la herida en comparación con las quemaduras de control.
[Lasers Med Sci. 2013 May;28(3):941-5. doi: 10.1007/s10103-012-1182-4. Epub 2012 Aug 16.]
El láser de diodo de bajo nivel acelera la recuperación de heridas.
Resumen
En este artículo se estudió el efecto del tiempo de iluminación de la herida mediante láser de diodo pulsado en el proceso de recuperación de la herida. Para este propósito, se reconstruyó el circuito de accionamiento electrónico original de un láser de diodo CW de longitud de onda de 650 nm para obtener un láser de salida pulsada con un ciclo de trabajo del 50 % y una frecuencia de repetición de pulso de 1 MHz. Se utilizaron veinte ratones macho de 3 meses de edad para seguir el efecto de la fotobioestimulación láser en el progreso del equilibrio energético de la herida. Se subdividieron en dos grupos y luego se hicieron las heridas en los lados traseros bilaterales de cada ratón. Se realizaron dos sesiones de láser pulsado durante 15 días. Las heridas de cada grupo de ratones se iluminaron con este láser pulsado durante 12 o 18 minutos por sesión durante estos 12 días. Los resultados de este estudio se compararon con los resultados de nuestro estudio anterior de método de equilibrio de energía para heridas utilizando el mismo tipo de láser. Las heridas de los ratones en ese estudio recibieron solo 5 minutos de solución de tiempo de iluminación en el primer y segundo día del proceso de equilibrio energético. En este estudio, encontramos que las heridas que se iluminaron durante 12 min/sesión se trataron aproximadamente 3 días antes que aquellas que se iluminaron durante 18 min/sesión. Ambos fueron tratados antes, entre 10 y 11 días, que el grupo de control.
[Photomed Laser Surg. 2009 Dec;27(6):959-64. doi: 10.1089/pho.2008.2366]
Un método láser de bajo nivel que utiliza un láser de diodo infrarrojo pulsado de 80 Hz acelera el equilibrio de la energía de quemaduras de tercer grado en ratas.
Resumen
La revisión de la literatura indica que la LLLT tiene un efecto bioestimulador en la recuperación de la herida, aunque todavía no se puede hacer una recomendación clara.
Se dividieron cuarenta y ocho ratas macho en los grupos 1 y 2. El día 0, se realizaron tres quemaduras de tercer grado en el dorso de cada rata utilizando vapor. En el grupo 1, la primera quemadura fue expuesta a un láser de diodo infrarrojo de 890 nm pulsado a 80 Hz a 0,396 J/cm2 tres veces por semana. En el grupo 2, la primera quemadura fue expuesta al láser inactivado. En ambos grupos, las segundas quemaduras fueron atendidas con la aplicación tópica de nitrofurazona al 0,2%, y las terceras quemaduras no recibieron ningún balance energético y se consideraron quemaduras de control. Las quemaduras fueron examinadas clínicamente. Las ratas recibieron ayuda durante 8, 12 y 20 días en ambos grupos. Los días 8, 2 y 20 se recogieron y analizaron muestras microbiológicas de quemaduras. Los datos se analizaron mediante el método de chi-cuadrado.
RESULTADOS:
La prueba t de Student pareada mostró que la tasa de cierre de heridas de las quemaduras asistidas por láser (17,6/-1,86 días) fue significativamente mayor que la de las quemaduras de control (19,6/-0,81 días) (p=0,007). Las quemaduras con ayuda que se cerraron fueron significativamente mayores que las de los controles. Las pruebas de chi-cuadrado mostraron que no hubo diferencia significativa entre cada microorganismo (Staphylococcus epidermis, S. aureus y Pseudomonas aeruginosa).
CONCLUSIÓN:
LLLT utilizando un láser de diodo infrarrojo pulsado de 80 Hz aceleró el equilibrio de energía de quemaduras de tercer grado en ratas.
(El) aspecto más importante del equilibrio energético de las quemaduras graves es cerrar la herida lo más rápido posible.
Advertencias
- El Láser Frío Spooky2 utiliza láseres reales.
- No se debe utilizar un método láser frío si está embarazada.
- No lo use sobre una persona sospechosa de padecer de la tiroides.
- No apunte ningún láser directamente a los ojos, ya que esto puede causar daños permanentes.
- No utilice una salida potenciada de Spooky2 Boost. El alto voltaje dañará el dispositivo




















Reviews
There are no reviews yet.